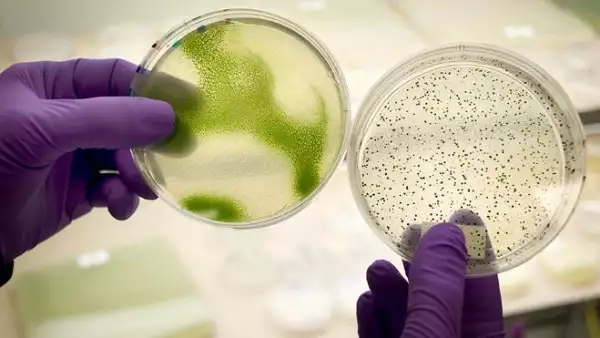

Empeora crisis aérea por adeudos en Venezuela

Los problemas que enfrentan las aerolíneas internacionales en Venezuela ponen en riesgo cerca de 15 mil empleos directos y 70 mil indirectos en la industria local.
María Lucila Beltrán, presidenta de la Asociación Venezolana de Agencias de Viajes y Turismo (Avavit), resaltó que la deuda del gobierno con las aerolíneas tiene prácticamente paralizada la venta de boletos.
La líder gremial consideró que la situación con las líneas aéreas debería resolverse porque las agencias de viaje generan unos "15 mil empleos directos pero a nivel indirecto son muchisísimos más, podríamos estar hablando de unos 70 ó 75 mil".
"La actividad nuestra sí está impactada porque la venta de boletos está prácticamente parada, no podemos vender cupos porque han bajado muchos vuelos, hay mucha menos disponibilidad", en plena época vacacional, resaltó.
Cifras extraoficiales estiman que el gobierno venezolano adeuda unos cuatro mil millones de dólares a las líneas aéreas, que se ven imposibilitadas de convertir a dólares, los bolívares en que vendieron sus boletos para enviarlos a sus casas matrices.
"A nivel de agencias de viajes sí estamos muy preocupados por el hecho de que no estamos vendiendo boletos y eso genera un grave problema para todo el gremio", referí la presidenta de AVAVIT.
Esto ha causado un encarecimiento significativo de los boletos aéreos y una caída drástica en la venta de pasajes, aunque el ministro de Turismo, Andrés Izarra, indicó que esta situación ha causado un incremento del turismo doméstico.
Beltrán enfatizó, ante la escasez de boletos hacia el exterior, "el turismo interno se ha incrementado bastante. A nivel nacional se nota que los vuelos están llenos y eso sí se ve un aumento", pese a que la AVAVIT carece de cifras exactas.
La presidenta de la Avavit admitió que encontrar una solución es "difícil" debido a la situación económica actual de Venezuela, pero se mostró esperanzada de alcanzar una solución que permita regularizar la actividad de las agencias de viaje.
"Para nosotros, que las líneas aéreas empiecen a abrir sus cupos, que me imagino que no lo abrirán de un día para otro sino que lo harán poco a poco, pero no importa, que se vaya regularizando la situación lo antes posible y lo mejor posible es lo que todos deseamos", dijo.
*Información de Notimex